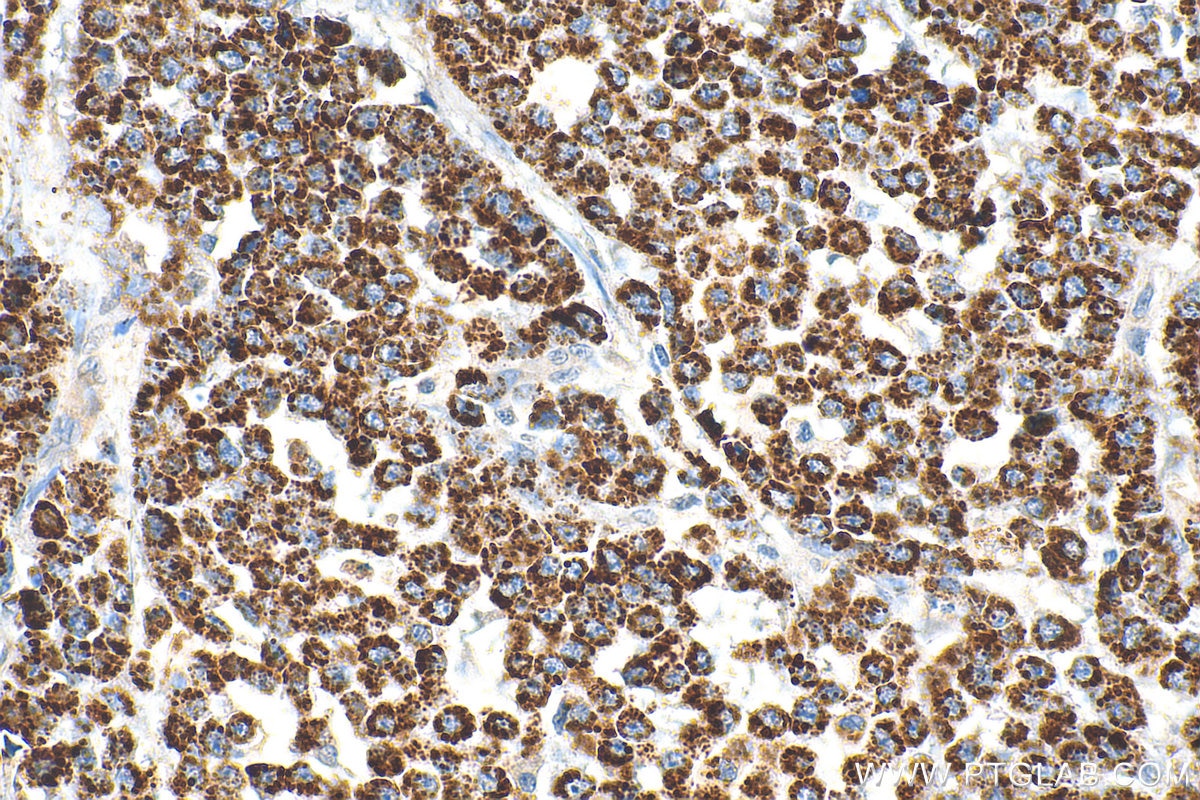

Tested Applications
| Positive WB detected in | COLO 320 cells, HeLa cells, human brain tissue, mouse embryo tissue, mouse liver tissue, NIH/3T3 cells, HT-1080 cells,mouse brain tissue, rat brain tissue |
| Positive IP detected in | mouse brain tissue |
| Positive IHC detected in | human colon cancer tissue, human prostate cancer tissue Note: suggested antigen retrieval with TE buffer pH 9.0; (*) Alternatively, antigen retrieval may be performed with citrate buffer pH 6.0 |
| Positive IF/ICC detected in | HepG2 cells, MCF-7 cells |
Recommended dilution
| Application | Dilution |
|---|---|
| Western Blot (WB) | WB : 1:1000-1:4000 |
| Immunoprecipitation (IP) | IP : 0.5-4.0 ug for 1.0-3.0 mg of total protein lysate |
| Immunohistochemistry (IHC) | IHC : 1:200-1:800 |
| Immunofluorescence (IF)/ICC | IF/ICC : 1:200-1:800 |
| It is recommended that this reagent should be titrated in each testing system to obtain optimal results. | |
| Sample-dependent, Check data in validation data gallery. | |
Published Applications
| KD/KO | See 12 publications below |
| WB | See 49 publications below |
| IHC | See 12 publications below |
| IF | See 12 publications below |
| IP | See 7 publications below |
| CoIP | See 1 publications below |
Product Information
13108-1-AP targets PYCR1 in WB, IHC, IF/ICC, IP, CoIP, ELISA applications and shows reactivity with human, mouse, rat samples.
| Tested Reactivity | human, mouse, rat |
| Cited Reactivity | human, mouse, zebrafish |
| Host / Isotype | Rabbit / IgG |
| Class | Polyclonal |
| Type | Antibody |
| Immunogen |
CatNo: Ag3764 Product name: Recombinant human PYCR1 protein Source: e coli.-derived, PGEX-4T Tag: GST Domain: 1-171 aa of BC022244 Sequence: MEQLLSSVGFCTEVEEDLIDAVTGLSGSGPAYAFTALDALADGGVKMGLPRRLAVRLGAQALLGAAKMLLHSEQHPGQLKDNVSSPGGATIHALHVLESGGFRSLLINAVEASCIRTRELQSMADQEQVSPAAIKKTILDKVKLDSPAGTALSPSGHTKLLPRSLAPAGKD Predict reactive species |
| Full Name | pyrroline-5-carboxylate reductase 1 |
| Calculated Molecular Weight | 319 aa, 33.8 kDa |
| Observed Molecular Weight | 33 kDa, 35 kDa |
| GenBank Accession Number | BC022244 |
| Gene Symbol | PYCR1 |
| Gene ID (NCBI) | 5831 |
| RRID | AB_2174878 |
| Conjugate | Unconjugated |
| Form | Liquid |
| Purification Method | Antigen affinity purification |
| UNIPROT ID | P32322 |
| Storage Buffer | PBS with 0.02% sodium azide and 50% glycerol, pH 7.3. |
| Storage Conditions | Store at -20°C. Stable for one year after shipment. Aliquoting is unnecessary for -20oC storage. 20ul sizes contain 0.1% BSA. |
Background Information
PYCR1,also named as P5CR1, belongs to the pyrroline-5-carboxylate reductase family. It is a housekeeping enzyme that catalyzes the last step in proline biosynthesis. PYCR1 can utilize both NAD and NADP, but has higher affinity for NAD. It is involved in the cellular response to oxidative stress. Mutation in PYCR1 will cause ARCL type II(ARCL2B ). Some mutation will cause DeBarsy syndrome (DBS) which is characterized by progeroid features, ophthalmological abnormalities, intrauterine growth retardation, and cutis laxa. The MW of PYCR1 is about 33-35 kDa. PYCR1 has 3 isoforms produced by alternative splicing. This antibody may have cross reaction to PYCR2 due to the high homology.
Protocols
| Product Specific Protocols | |
|---|---|
| IF protocol for PYCR1 antibody 13108-1-AP | Download protocol |
| IHC protocol for PYCR1 antibody 13108-1-AP | Download protocol |
| IP protocol for PYCR1 antibody 13108-1-AP | Download protocol |
| WB protocol for PYCR1 antibody 13108-1-AP | Download protocol |
| Standard Protocols | |
|---|---|
| Click here to view our Standard Protocols |
Publications
| Species | Application | Title |
|---|---|---|
Nature Tumour-specific proline vulnerability uncovered by differential ribosome codon reading.
| ||
Nature Functional genomics reveal that the serine synthesis pathway is essential in breast cancer. | ||
J Hepatol Metabolic pathway analyses identify proline biosynthesis pathway as a promoter of liver tumorigenesis. | ||
Neuron Loss of PYCR2 Causes Neurodegeneration by Increasing Cerebral Glycine Levels via SHMT2. |
Reviews
The reviews below have been submitted by verified Proteintech customers who received an incentive for providing their feedback.
FH Hyeonju (Verified Customer) (05-13-2024) | Too many non-specific bands are captured. ? I'm curious what the band is under pycr1 in lanes 6-9. Can you send me information about other proteins that react with the pycr1 antibody(if you have information about this)
![]() |
FH Daniel (Verified Customer) (02-05-2020) | The antibody stained the glomerulus of the mouse kidney.
![]() |